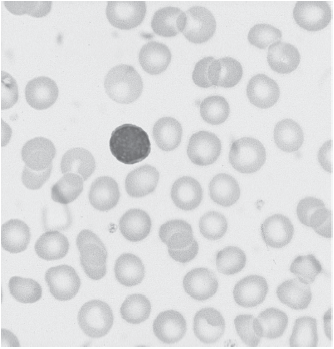
Enunciado 3142714-1

Os glóbulos brancos ou leucócitos são as células de defesa do organismo. No sangue circulante, é possível encontrar diferentes tipos de leucócitos que são diferenciados entre si de acordo com sua morfologia.
Fonte: BAIN, B.Células sanguíneas - um guia prático. 5. ed. 2016.
A figura refere-se a uma fotomicroscopia de uma distensão de sangue periférico de um paciente saudável. Nela, é possível observar um tipo específico de leucócito denominado